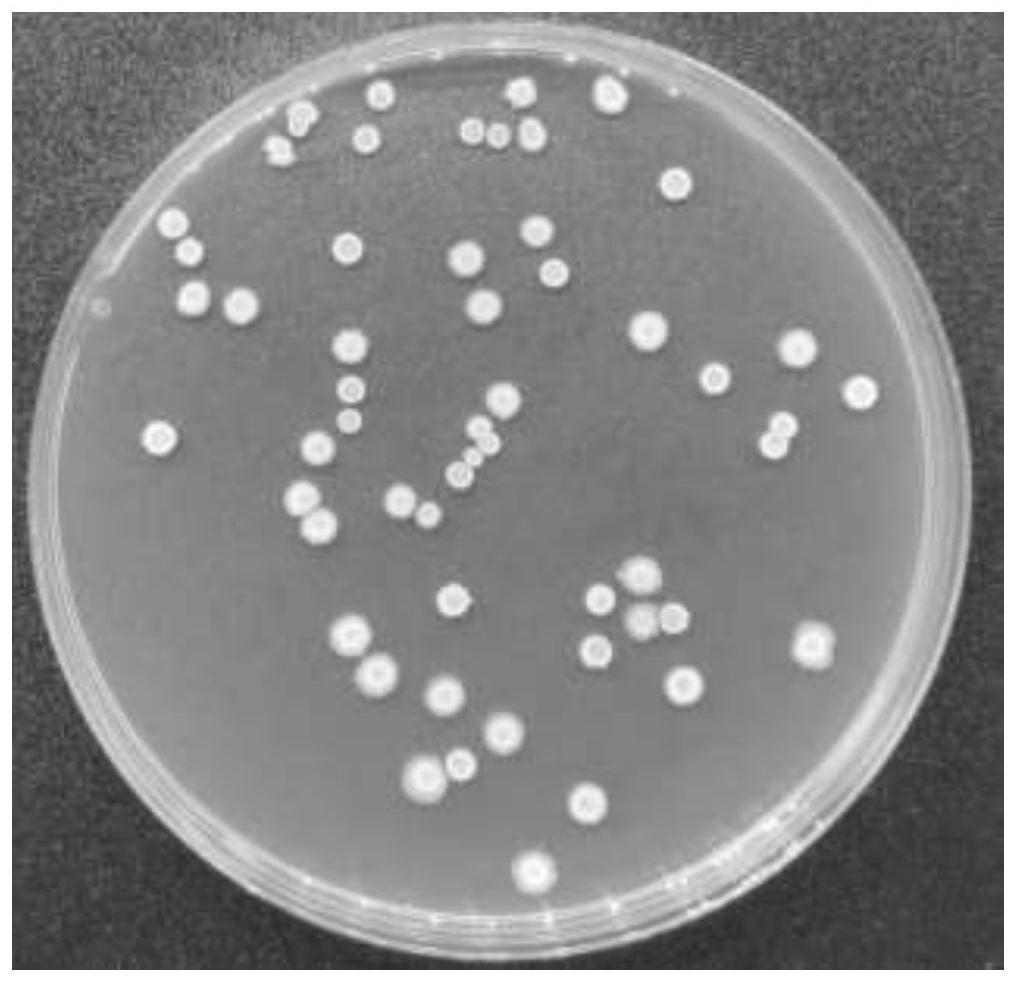

实验技术服务-基因编辑
依托成熟的基因编辑技术平台,我们提供精准高效的干扰、过表达、敲除及文库筛选服务,助力基因功能研究与药物开发。干扰服务:通过 siRNA/miRNA 设计,特异性沉默靶基因,实现瞬时或稳定干扰,效率可达 90% 以上;过表达服务:构建重组载体,实现目的基因高效表达,支持多种启动子与标签选择;敲除服务:基于 CRISPR/Cas9 技术,实现靶基因精准敲除,提供单克隆筛选与测序验证;文库筛选:涵盖 sgRNA/ORF 等定制化文库,结合高通量筛选系统,快速定位功能基因;从单基因操作到全基因组筛选,全程质控保障数据可靠性,为科研团队提供从设计到交付的一站式解决方案

问题反馈
如果您有产品相关疑问,可以留下您的问题和联系方式,我们会及时联系您!

联系我们
技术支持:
support@neorabio.cn